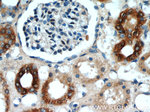
ANGPTL4 Antibody in Immunohistochemistry (Paraffin) (IHC (P))

Search
Proteintech
ANGPTL4 Polyclonal Antibody
{{$productOrderCtrl.translations['antibody.pdp.commerceCard.promotion.promotions']}}
{{$productOrderCtrl.translations['antibody.pdp.commerceCard.promotion.viewpromo']}}
{{$productOrderCtrl.translations['antibody.pdp.commerceCard.promotion.promocode']}}: {{promo.promoCode}} {{promo.promoTitle}} {{promo.promoDescription}}. {{$productOrderCtrl.translations['antibody.pdp.commerceCard.promotion.learnmore']}}
产品信息
18374-1-AP
种属反应
已发表种属
宿主/亚型
分类
类型
抗原
偶联物
形式
浓度
规格
纯化类型
保存液
内含物
保存条件
运输条件
产品详细信息
Immunogen sequence: MSGAPTAGA ALMLCAATAV LLSAQGGPVQ SKSPRFASWD EMNVLAHGLL QLGQGLREHA ERTRSQLSAL ERRLSACGSA CQGTEGSTDL PLAPESRVDP EVLHSLQTQL KAQNSRIQQL FHKVAQQQRH LEKQHLRIQH LQSQFGLLDH KHLDHEVAKP ARRKRLPEMA QPVDPAHNVS RLHRLPRDCQ ELFQVGERQS GLFEIQPQGS PPFLVNCKMT SDGGWTVIQR RHDGSVDFNR PWEAYKAGFG DPHGEFWLGL EKVHSITGDR NSRLAVQLRD WDGNAELLQF SVHLGGEDTA YSLQLTAPVA GQLGATTVPP SGLSVPFSTW DQDHDLRRDK NCAKSLSGGW WFGTCSHSNL NGQYFRSIPQ QRQKL (1-374 aa encoded by BC023647)
靶标信息
Angiopoietin-like protein 4 (ANGPTL4), is a secreted protein selectively expressed in adipose tissue, liver, and placenta1-3 that plays a variety of roles in vivo, ranging from adipogenesis to angiogenesis to carcinogenesis. The expression of ANGPTL4 is also under nutritional and hormonal control. ANGPTL4 has been observed to induce a strong pro-angiogenic response independent of vascular endothelial growth factor (VEGF), and its expression has been described in hypoxic human tissues as well as a variety of cancers, including liposarcoma, hepatocellular carcinoma, and conventional renal cell carcinoma.
仅用于科研。不用于诊断过程。未经明确授权不得转售。
生物信息学
蛋白别名: 425O18-1; Angiopoietin-like protein 4; Angiopoietin-related protein 4; ANGPTL2; contains fibrinogen-like domain; Fasting-i; Fasting-induced adipose factor; fibrinogen/angiopoietin-related protein; hepatic angiopoietin-related protein; Hepatic fibrinogen/angiopoietin-related protein; HFARP; major histocompatibility complex region NG27; peroxisome proliferator-activated receptor (PPAR) gamma induced angiopoietin-related protein; PPARG angiopoietin related protein; Secreted protein Bk89; unnamed protein product
基因别名: ANGPTL4; ARP4; Bk89; Farp; FIAF; HARP; HFARP; Ng27; NL2; PGAR; Pgarg; PP1158; PSEC0166; TGQTL; UNQ171; UNQ171/PRO197
UniProt ID: (Human) Q9BY76, (Mouse) Q9Z1P8
Entrez Gene ID: (Human) 51129, (Mouse) 57875